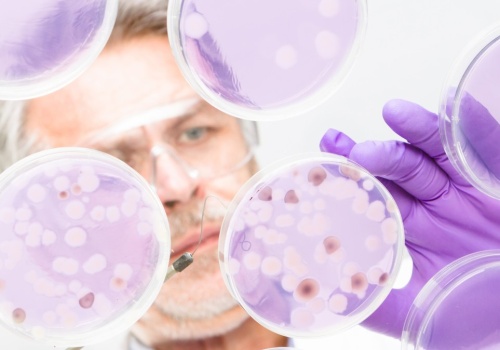
Naturalny kompas w bakteriach. Magnetosomy pomagają w orientacji

Zespół naukowców z Uniwersytetu w Bazylei przyjrzał się bliżej bakterii Magnetospirillum gryphiswaldense, która potrafi orientować się zgodnie z polem magnetycznym Ziemi dzięki obecności magnetosomów. Badania pozwoliły określić siłę magnetyczną tych struktur i ich wpływ na ruch bakterii. Odkrycia mo...
źródło: https://geekweek.interia.pl/nauka/news-naturalny-kompas-w-bakteriach-magnetosomy-pomagaja-w-orienta,nId,22604866
dodano: 01-03-2026 07:42:06
Inne znaleziska:
Reforma szkolnictwa: "Kompas Jutra" zaskoczy nauczycieli i uczniów
Reforma szkolnictwa: "Kompas Jutra" zaskoczy nauczycieli i uczniów
Mamy wielkie marzenia, by polska szkoła była najlepsza w Europie i na świecie. I to się wydarzy dzięki reformie "Kompas Jutra", która od 2026 r. wejdzie do polskich szkół - zapowiada ministra edukacji Barbara Nowacka w nagraniu przygotowanym na rozpo...
rmf24.pl
31-08-2025 11:31:13
31-08-2025 11:31:13
Zrobił kompas z Minecrafta, który wygląda jak w grze i działa jak prawdziwy
Zrobił kompas z Minecrafta, który wygląda jak w grze i działa jak prawdziwy
Wirtualne przedmioty z gier nie zawsze trafiają do rzeczywistości, ale jak już się pojawią, to potrafią "robić robotę". Tak właśnie jest w przypadku jednego najbardziej rozpoznawalnych gadżetów z Minecrafta - kompasu. Z pozoru proste narzędzie, które...
interia.pl
21-10-2025 01:19:13
21-10-2025 01:19:13
Reforma26. Kompas Jutra. Ruszają konsultacje publiczne nowych podstaw programowych
Reforma26. Kompas Jutra. Ruszają konsultacje publiczne nowych podstaw programowych
Do konsultacji publicznych, które potrwają do 18 grudnia br., kierujemy projekty rozporządzeń Ministra Edukacji w sprawie podstawy programowej wychowania przedszkolnego i podstawy programowej kształcenia ogólnego dla szkoły podstawowej oraz ramowego...
kielce.pl
20-11-2025 09:27:09
20-11-2025 09:27:09
Reforma „Kompas Jutra”. MEN otwiera konsultacje nowych podstaw programowych
Reforma „Kompas Jutra”. MEN otwiera konsultacje nowych podstaw programowych
Ministerstwo Edukacji Narodowej rozpoczęło kolejny etap prac nad Reformą26 „Kompas Jutra”. 19 listopada 2025 roku do konsultacji publicznych trafiły projekty nowych podstaw programowych, które będą obowiązywać w szkołach w kolejnych latach. Konsultac...
edukacja.rp.pl
20-11-2025 15:18:09
20-11-2025 15:18:09
Zepsuta opoka Zachodu. Czy USA straciły kompas? "Naprawdę muszą posprzątać we własnym domu"
Zepsuta opoka Zachodu. Czy USA straciły kompas? "Naprawdę muszą posprzątać we własnym domu"
Ameryka, która przez dekady była filarem świata demokratycznego, dziś sama chwieje się w posadach. Zamiast stabilnego przywództwa koncentracja władzy, zamiast konstytucji — polityczna wolna amerykanka. Sojusznicy coraz wyraźniej widzą, że parasol bez...
wiadomosci.onet.pl
13-12-2025 19:58:14
13-12-2025 19:58:14
Kolejne weto Nawrockiego. Ujawniamy jak naprawdę wyglądało spotkanie ws. reformy edukacji „Kompas Ju...
Kolejne weto Nawrockiego. Ujawniamy jak naprawdę wyglądało spotkanie ws. reformy edukacji „Kompas Jutra”
Prezydent Karol Nawrocki poinformował, że ZAWETOWAŁ reformę edukacji „Kompas Jutra”. Ujawniamy jak naprawdę wyglądało wczorajsze spotkanie Gabinetu Prezydenta w tej sprawie w Pałacu Prezydenckim. „Prezydent stał przed wyborem: zablokować początek sen...
kronika24.pl
19-12-2025 00:15:41
19-12-2025 00:15:41
Szkoła na Nowo: Kompas Jutra mimo weta. Barbara Nowacka o reformie, zarobkach i pracach domowych
Szkoła na Nowo: Kompas Jutra mimo weta. Barbara Nowacka o reformie, zarobkach i pracach domowych
Prezydent zawetował ustawę o reformie oświaty, ale MEN zapowiada, że zmiany i tak wejdą w życie. Jak ma wyglądać szkoła po reformie? Co z wynagrodzeniami nauczycieli, małymi szkołami i edukacją zdrowotną? Pytamy o to w podcaście „Szkoła na nowo” szef...
edukacja.rp.pl
16-02-2026 13:34:09
16-02-2026 13:34:09
O reformie „Kompas Jutra” mówiła minister edukacji Barbara Nowacka podczas spotkania z nauczycielami...
O reformie „Kompas Jutra” mówiła minister edukacji Barbara Nowacka podczas spotkania z nauczycielami w Szewnie
Minister edukacji narodowej Barbara Nowacka w poniedziałek, 16 lutego w Zespole Szkół Publicznych w Szewnie spotkała się z nauczycielami, dyrektorami szkół z kilku powiatów w regionie świętokrzyskim, a później z rodzicami, by przedstawić założenia Re...
radioostrowiec.pl
16-02-2026 22:23:15
16-02-2026 22:23:15
Nowe przedmioty, odchudzenie podstawy programowej, więcej praktyki i większa kreatywność w nauczaniu to niektóre zmiany, jakie ma przynieść reforma systemu szkolnictwa pod nazwą "Kompas Jutra". Ma wejść w życie w nowym roku szkolnym.Chodzi o przygoto...
radioszczecin.pl
04-03-2026 16:57:05
04-03-2026 16:57:05
Nowy rok szkolny z dużą zmianą. MEN pokazuje plan na Kompas Jutra
Nowy rok szkolny z dużą zmianą. MEN pokazuje plan na Kompas Jutra
Polska szkoła stoi przed dużą zmianą. Ministerstwo Edukacji zapowiada reformę Kompas Jutra, która ma lepiej przygotować uczniów do życia we współczesnym świecie, ale zmiany mają być wprowadzane stopniowo. Nowe rozwiązania mają połączyć zdobywanie wie...
edziecko.pl
05-03-2026 17:23:06
05-03-2026 17:23:06